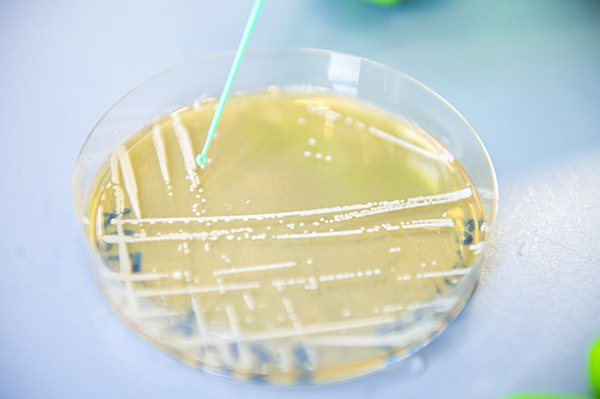

Équipe
Epigénétique translationnelle
Dpt: Signalisation et Chromatine
Nos activités de recherche
Origine et positionnement. Créée en 2012 par Jérôme Govin à l’Institut de Biologie Structurale et des Biotechnologies de Grenoble (BIG), l’équipe s’est spécialisée dans l’étude des voies de signalisation épigénétique, notamment l’acétylation des histones et les bromodomaines. Depuis 2018, elle est rattachée au département Signaling Through Chromatin de l’Institut pour l’Avancée des Biosciences (IAB), et intègre un programme translationnel en onco-hématologie dirigé par Anouk Emadali, en lien avec des cliniciens du CHU Grenoble Alpes.
Axes de recherche. Nos travaux visent à comprendre comment les mécanismes épigénétiques régulent le destin cellulaire, en conditions physiologiques (différenciation des gamètes chez la levure et les mammifères) et pathologiques (infections fongiques, lymphomes B agressifs). Nous combinons biologie cellulaire, biochimie, protéomique, biologie structurale et bioinformatique pour explorer ces mécanismes dans des modèles fondamentaux et cliniques.
Approche translationnelle. Notre équipe réunit une expertise en biologie, en épigénétique et en clinique, avec sept médecins hospitaliers, dont Sylvain Carras (PU-PH), également directrice adjointe de la DRCI et du CRB du CHU Grenoble. L’ancrage hospitalier et l’alignement avec les axes stratégiques du CHU (épigénétique, cancer, infertilité) permettent de mener des projets à fort potentiel translational. Nous contribuons aussi aux actions nationales via notre participation au comité scientifique de la LYSA.
Dynamique collective. Nous animons activement la communauté épigénétique grenobloise, notamment sur le Campus Santé. Sous la direction de Jérôme Govin, nous menons des actions structurantes telles que le club d’épigénétique de Grenoble, les rencontres « Interface Clinics & Epigenetics », et le partenariat stratégique IAB–EMBL.
Nos axes de recherche
Notre équipe explore les voies de signalisation de la chromatine et leur dérégulation dans les maladies humaines. Nous étudions en particulier comment les facteurs de la chromatine contrôlent l’organisation du génome, l’expression des gènes et l’identité cellulaire. Ces mécanismes sont largement conservés au cours de l’évolution, des levures jusqu’à l'homme.
En savoir plus
À la croisée de l’épigénétique et de la médecine : une approche translationnelle des maladies humaines
En savoir plusNos publications majeures
Voir toutes les publicationsNos activités en images
Nos collaborations
- Carlo Petosa, Institute of Structural Biology (IBS)
- Charles McKenna, USC Los Angeles, USA
- Guillermo Orsi, IAB
- Julien Thévenon, IAB
- Genaël Rabut, IGDR, Rennes
- Dominique Helmlinger, CRBM, Montpellier
Nos technologies
- Molecular and cellular biology
- Cell culture
- Yeast genetics and biochemistry
- B cell lymphomas
- Advances epigenomics (RNA-seq, ChIP-seq, ATAC-seq, Cut&Run-seq, etc)
- Bioinformatic analysis